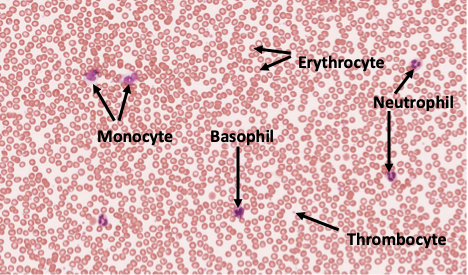
Histology slide of blood sample with labeled formed elements
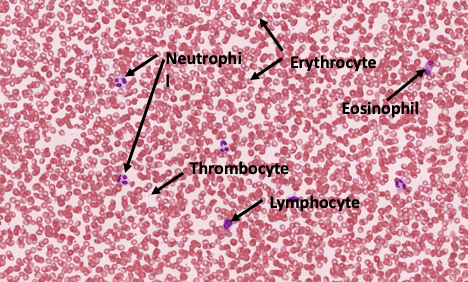
Histology slide of blood smaple with labeled formed elements

Lab 3: Blood
Table of Contents
- Preparation for lab
- Learning outcomes of the lab exercises
- Today’s Activities
- Blood
- Blood Typing
- Blood Word Bank
- Optional Material
Preparation for lab
To get the most out of this lab you need to be prepared. The basic knowledge needed for this lab is covered in Amerman “Human Anatomy and Physiology” in Chapter 19 “Blood”, or chapter 18 in OpenStax.
Learning outcomes of the lab exercises:
- Identify each type of blood cell and their basic functions.
- Identify an individual’s blood type.
- Describe how blood typing works.
Today’s Activities
- Identify at least one of each blood cell type via microscopy.
- Complete the blood typing game online: https://educationalgames.nobelprize.org/educational/medicine/bloodtypinggame/gamev3/index.html
- Complete the blood typing activity.
- Complete the lab report.
- Your instructor may have additional blood tests available depending on availability of supplies and time
Blood
Overview
Blood is a specialized connective tissue that circulates throughout the body to sustain life by transporting essential substances and maintaining internal balance. It is composed of plasma (the liquid extracellular matrix), red blood cells, white blood cells, and platelets. Red blood cells carry oxygen from the lungs to tissues and return carbon dioxide for removal, white blood cells support the immune system by defending against infection, and platelets help with blood clotting to prevent excessive bleeding. Together, these components allow blood to deliver nutrients and hormones, remove waste products, regulate body temperature and pH, and protect the body from injury and disease.
Blood Plasma
Blood plasma is the liquid component of blood that makes up about 55% of its total volume and serves as the medium in which blood cells are suspended. It is composed mostly of water, along with proteins such as albumin, globulins, and fibrinogen, as well as electrolytes, nutrients, hormones, gases, and waste products. Plasma plays a vital role in transporting these substances throughout the body, maintaining blood pressure and volume, regulating body temperature, and supporting clotting and immune functions. By distributing essential materials and removing wastes, blood plasma helps maintain homeostasis and ensures that cells and tissues function properly.
Formed Elements
Blood cells are the formed elements of blood and are produced primarily in the bone marrow through a process called hematopoiesis. They include red blood cells, white blood cells, and platelets, each with a specialized structure that supports its role in maintaining health. These cells circulate within the plasma and work together to transport substances, defend the body, and maintain the integrity of the circulatory system.

Red blood cells, or erythrocytes, are the most abundant blood cells and are responsible for transporting oxygen from the lungs to body tissues and carrying carbon dioxide back to the lungs for removal. They contain hemoglobin, an iron-rich protein that binds oxygen and gives blood its red color. Red blood cells lack a nucleus, which allows more space for hemoglobin and increases their efficiency in gas transport. Their flexible, biconcave shape helps them move easily through even the smallest blood vessels.
White blood cells, or leukocytes, play a key role in the immune system by protecting the body against pathogens and foreign substances. There are several types, including neutrophils, lymphocytes, monocytes, eosinophils, mast cells, and basophils, each with specific defensive functions such as engulfing bacteria, producing antibodies, or regulating inflammation. Platelets, also known as thrombocytes, are small cell fragments that help prevent blood loss by forming clots at sites of injury. Together, white blood cells and platelets support the body’s defense and repair systems, ensuring survival and recovery from injury or infection.

Blood Typing
Overview
Blood typing is the classification of blood based on specific antigens present on the surface of red blood cells and antibodies found in the plasma. The most important blood group systems are the ABO system (types A, B, AB, and O) and the Rh system (positive or negative), which together determine a person’s blood type. Blood typing is critical for safe blood transfusions, organ transplants, and pregnancy care, because incompatible blood types can trigger immune reactions that destroy red blood cells. By identifying compatible donors and recipients, blood typing helps prevent serious complications and ensures effective medical treatment.
How Blood Type is Determined
Blood typing is the process of classifying blood based on the presence or absence of specific molecules, called antigens, on the surface of red blood cells. These antigens are genetically inherited and vary among individuals, which is why people have different blood types. The most important blood group systems are the ABO system and the Rh system, both of which play a major role in medical procedures such as blood transfusions, organ transplants, and pregnancy care. Correct blood typing is essential because receiving incompatible blood can trigger a dangerous immune response in which the body attacks the transfused red blood cells.
The ABO blood group system is determined by the presence of A antigens, B antigens, both, or neither on red blood cells. People with type A blood have A antigens and anti-B antibodies in their plasma, type B blood has B antigens and anti-A antibodies, type AB blood has both antigens and no anti-A or anti-B antibodies, and type O blood has neither antigen but has both anti-A and anti-B antibodies. These naturally occurring antibodies are the reason some blood types cannot be safely mixed, as they can cause red blood cells to clump together and break apart, a reaction known as agglutination.
The Rh system is based primarily on the presence or absence of the Rh (D) antigen on red blood cells. If the Rh antigen is present, the blood type is Rh positive; if it is absent, the blood type is Rh negative. Blood typing in a laboratory is performed by mixing a small sample of blood with antibodies against A, B, and Rh antigens and observing whether agglutination occurs. The pattern of clumping reveals which antigens are present, allowing healthcare providers to determine a person’s blood type and ensure compatibility for transfusions and other medical needs.



Blood Word Bank
Essential
- Plasma
- Formed elements
- Erythrocyte
- Neutrophil
- Basophil
- Eosinophil
- Monocyte/Macrophage
- Lymphocyte
- T cell
- B cell
- Thrombocyte
- Type A blood
- Type B blood
- Type AB blood
- Type O blood
- Type Rh+ blood
- Type Rh- blood
Advanced
- Megakaryocyte
- Mast cell
- Natural killer cell
- Hematopoiesis
Mastery
- Lymphoid lineage
- Myeloid lineage
Optional Material
Hemoglobin
Hemoglobin (Hb) is the protein in RBCs responsible for transporting O₂ through the blood. Hb constitutes more than 95% of the non-water content inside RBCs. It has a quaternary protein structure consisting of four globular protein subunits. Each subunit contains an iron atom, which is the site of O₂ binding. When Hb binds O₂ its color is bright red (arterial blood). As O₂ is used in cells and little bound O₂ remains, the blood’s color is rather dark red (or blue if viewed through skin; venous blood). The color of a blood sample can be used to measure the amount of Hb in the blood. This quick and easy test is helpful to e.g. determine if a person suffers from anemia - a condition caused by a deficiency of red blood cells or of hemoglobin in the blood.
DIRECTIONS: When drawing small quantities of blood (a few drops), it is easiest and least painful to do so from the side of the fingertips. Have a paper towel handy to apply pressure against the skin after you obtain the samples for the tests you are performing. Open an alcohol prep pad and wipe the side of a lesser-used fingertip. Press the red tip of the safety lancet against the skin. The lancet will click as its internal needle penetrates the skin and retracts. Squeeze distally along the length of the finger to milk blood out of the wound. Wipe away the first blood that comes out with an alcohol pad. Once you have collected the necessary blood for each test, apply pressure against the wound with a paper towel to stop the bleeding.
To estimate Hb levels, soak a piece of chromatography paper with a drop of blood and allow it to dry. Next, compare the color of the blood spot to the Hemoglobin Color Scale to estimate the Hb content of the blood in g/dl. Normal hemoglobin levels are 12-15 g/dl for women and 14-17 g/dl for men. Could your subject be suffering from anemia?
Hematocrit

Hematocrit is the percent of blood volume that is occupied by RBCs. It is also called PCV or packed cell volume - which hints at how you determine it. A centrifuge is used to spin a blood sample, causing the heavy RBCs to ’pack’ into the bottom end of the capillary, whereas the the light, clear plasma (water, solutes, and light plasma proteins) stay at the top end. White blood cells and platelets are ’heavier’ than plasma, but not as ’heavy’ as RBCs and thus stay in middle - visible as the so called buffy coat.
As an alternative to testing your own blood, you can also use this online lab: https://www.humanbiomedia.org/hematocrit-lab-simulation/
DIRECTIONS: Fill a heparinized (heparin is a chemical that prevents blood form coagulating) capillary tube with a sample of blood (the more you can fill the capillary, the easier it will be to read of the hematocrit and the more precise the test will work!). Plug the bottom of the tube with the white clay found at your bench. Bring the tube to the front of the lab. The instructor will place the tube into the centrifuge and tell you which position in the centrifuge it is in. Once everyone’s sample is in the centrifuge, we will spin the blood at 10,000 RPM for 5 minutes. After the blood has been spun, find your tube and measure the hematocrit. The hematocrit is the % of packed red blood cells compared to the entire capillary content (RBCs, buffy coat, clear plasma). Use a sliding scale to read it! The scale either slides or spins so that the height of the blood sample in your tube can be lined up with the 100% marker on the scale. Normal hematocrit levels are 38% for women and 46% for men. Note your hematocrit. Is it within normal levels? How does it compare with the hemoglobin level you determined through the blood color?

Read of the hematocrit at the top end of the packed RBC (in this example 50%). Note: some sliding scales are designed to rotate.
Reading the hematocrit by sliding it on the scale: Align the bottom end of the packed RBC with the 0% line and the top of the clear portion (the plasma) with the (angled) 100% line.
Blood Sugar Levels
Besides the transport of gasses (e.g. O₂ and CO₂ ), blood also transports nutrients to the cells. Humans use the simple sugar glucose as the primary source of energy. Glucose is transported from the intestine or liver (where it is stored as glycogen) to all cells in the body to be ’burned’ by the mitochondria. The body uses the hormone insulin to regulate how much glucose is in the blood stream, the blood glucose level. A persistently low blood glucose level is called hypoglycemia. Persistently high levels are called hyperglycemia and characteristic for the disease Diabetes mellitus. Variations in blood sugar are normal over the course of the day, e.g. the blood sugar level quickly rises when we consume foods with a high Glycemic Index at lunch, however, after a few hours they should return to between 3.9 and 5.5 mmol/L (70 to 100 mg/dL).
DIRECTIONS:
- Insert a test strip into the blood glucose meter. This should turn the meter on. Once the meter has turned on and is ready for a blood sample, touch the test strip to your blood to draw some up onto the test strip. What is your blood glucose level?
- Eat some food with very high gycemic index - candy comes to mind. Wait for ~30 minutes.
- Repeat the blood glucose measurement. How did the value change?